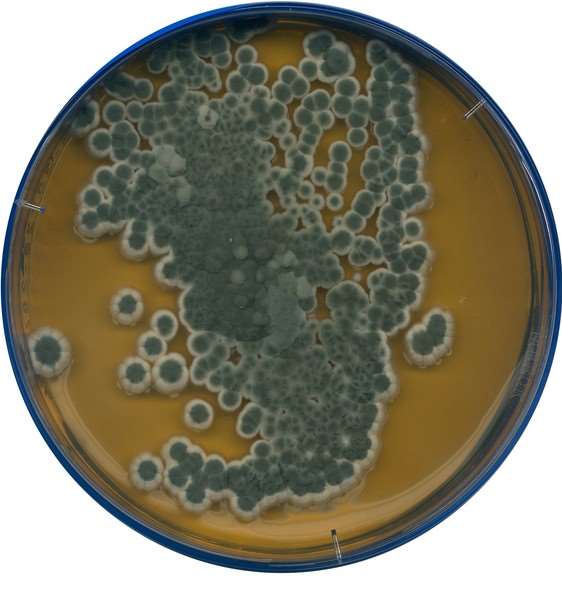
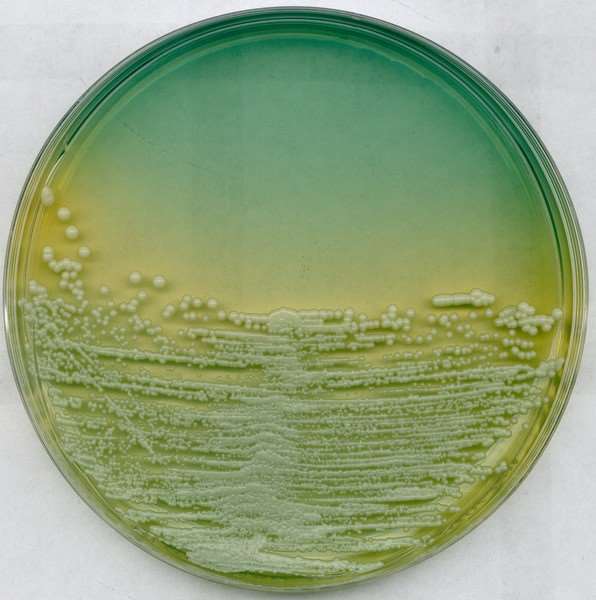
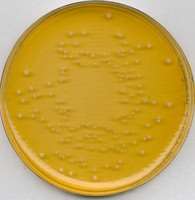

Hi,歡迎來到海西儀器城!
- 登錄
- 注冊
- 手機(jī)版

 APP StoreAndroid版
APP StoreAndroid版 - 關(guān)注精藝

您的報價需求已收到
您的報價需求已收到













